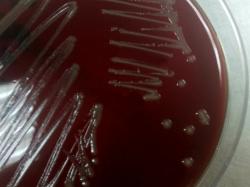

|
| Citrobacter braakii Gram-staining |
| Citrobacter braakii colonies on Sheep Blood Agar |
Taxonomy
Morphology
Cultural characteristics
Biochemical characters
Ecology
Pathogenicity
References
Phylum Pseudomonadota (Proteobacteria), Class Gammaproteobacteria, Order Enterobacterales, Family Enterobacteriaceae,
Genus Citrobacter, Citrobacter braakii Brenner et al. 1993.
Old synonym: Citrobacter genomospecies 6.
Genus Citrobacter, Citrobacter braakii Brenner et al. 1993.
Old synonym: Citrobacter genomospecies 6.
Gram-negative, straight rods, 1.0 x 2.0-6.0 μm, found singly or in pairs. Frequently
motile by means of peritrichous flagella. Usually not encapsulated.
motile by means of peritrichous flagella. Usually not encapsulated.
Colonies on nutrient agar are generally 2-4 mm in diameter, smooth, low convex,
moist, translucent or opaque, and gray with a shiny surface and entire edge. Mucoid
or rough forms may occur.
Facultatively anaerobic. Incubation temperature 37 °C.
Media: Trypticase Soy Agar with 5% sheep blood, Nutritive Agar. Grows on media that
inhibit Escherichia coli: Muller’s tetrathionate broth, Leifson’s selenite broth, Wilson-
Blair bismuth sulfite, Kristensen briliant green-phenol red agar.
moist, translucent or opaque, and gray with a shiny surface and entire edge. Mucoid
or rough forms may occur.
Facultatively anaerobic. Incubation temperature 37 °C.
Media: Trypticase Soy Agar with 5% sheep blood, Nutritive Agar. Grows on media that
inhibit Escherichia coli: Muller’s tetrathionate broth, Leifson’s selenite broth, Wilson-
Blair bismuth sulfite, Kristensen briliant green-phenol red agar.
Isolated from human and animal stools and clinical samples (blood, peritoneal
fluid, nail abscess).
fluid, nail abscess).
Opportunistic pathogen. Cases of bacteremia in patients with multiple comorbidities
were reported.
were reported.
- J. G. Holt et al., 1994. Facultatively Anaerobic Gram-Negative Rods. Subgroup 1. Family Enterobacteriaceae. In: Begey’s Manual of
Determinative Bacteriology, 9th-edition, Williams & Wilkins, pp 175-189. - Don J. Brenner and J.J. Farmer III, 2001. Family I. Enterobacteriaceae. In: Bergey’s Manual of Systematic Bacteriology, Second
edition, Vol two, part B, George M. Garrity (Editor-in-Chief), pp 587-897. - Werkman (C.H.) and Gillen (G.F.): Bacteria producing trimethylene glycol. Journal of Bacteriology,1932, 23,167-182
- Ewing(W.H.) and Davis (B.R.): Biochemical characterization of Citrobacter diversus (Burkey) Werkman and Gillen and designation
of the neotype strain. Int. J. Syst. Bacteriol., 1972, 22, 12-18. - Abbot SL, Klebsiella, Enterobacter, Citrobacter, Serratia, Plesiomonas, and other Enterobacteriaceae. In: Murray PR, Baron EJ,
Jorgensen JH, Pfaller MA, Yolken RH. Manual of clinical microbiology. 8th edition. Washington DC: American Society for
Microbiology, 2003:684-700 - Don J. Brenner. Biochemical Identification of citrobacter Species Defined by DNA Hybridization and Description of Citrobacter
gillenii sp. nov. (formerly C. genomospecies 10) and C. murliniae sp. nov. (formerly Citrobacter genomospecies 11), Journal of
Clinical Microbiology Aug. 1999, p. 2619–2624, Vol. 37, No. 8. - Adeolu M, Alnajar S, Naushad S, S Gupta R. Genome-based phylogeny and taxonomy of the 'Enterobacteriales': proposal for
Enterobacterales ord. nov. divided into the families Enterobacteriaceae, Erwiniaceae fam. nov., Pectobacteriaceae fam. nov.,
Yersiniaceae fam. nov., Hafniaceae fam. nov., Morganellaceae fam. nov., and Budviciaceae fam. nov. Int J Syst Evol Microbiol
2016; 66:5575-5599. - Oberhettinger P, Schule L, Marschal M, Bezdan D, Ossowski S, Dorfel D, Vogel W, Rossen JW, Willmann M, Peter S. Description
of Citrobacter cronae sp. nov., isolated from human rectal swabs and stool samples. Int J Syst Evol Microbiol 2020; 70:2998-3003. - Ribeiro TG, Clermont D, Branquinho R, Machado E, Peixe L, Brisse S. Citrobacter europaeus sp. nov., isolated from water and
human faecal samples. Int J Syst Evol Microbiol 2017; 67:170-173. - Clermont D, Motreff L, Passet V, Fernandez JC, Bizet C, Brisse S. Multilocus sequence analysis of the genus Citrobacter and
description of Citrobacter pasteurii sp. nov. Int J Syst Evol Microbiol 2015; 65:1486-1490. - Ribeiro TG, Goncalves BR, da Silva MS, Novais A, Machado E, Carrico JA, Peixe L. Citrobacter portucalensis sp. nov., isolated from
an aquatic sample. Int J Syst Evol Microbiol 2017; 67:3513-3517. - Ribeiro TG, Izdebski R, Urbanowicz P, Carmeli Y, Gniadkowski M, Peixe L. Citrobacter telavivum sp. nov. with chromosomal mcr-9
from hospitalized patients. Eur J Clin Microbiol Infect Dis 2021; 40:123-131. - Oyeka M, Antony S. Citrobacter braakii Bacteremia: Case Report and Review of the Literature. Infect Disord Drug Targets. 2017;17
(1):59-63. doi: 10.2174/1871526516666161005155847. PMID: 27658860. - Francesk Mulita, Nikolaos Parchas, Levan Tchabashvili, et al. Green Nail Syndrome caused by Citrobacter braakii. Authorea.
March 19, 2021. DOI: 10.22541/au.161615615.50581966/v1. - Carlini A, Mattei R, Mazzotta L, et al. Citrobacter braakii, an Unusual Organism as Cause of Acute Peritonitis in PD Patients.
Peritoneal Dialysis International. 2005;25(4):405-406. doi:10.1177/089686080502500417
Positive results for methyl red, nitrate reduction, Tartrate (Jordans), acid production
from: glucose (with gas), L-arabinose, maltose, L-rhamnose, trehalose, D-xylose,
D-mannitol, mannose and D-sorbitol.
Negative results fo oxidase, lysine decarboxylase, Voges-Proskauer, phenylalanine,
gelatinase, deoxyribonuclease, lipase, acid production from: erythritol and
myo-inositol.
from: glucose (with gas), L-arabinose, maltose, L-rhamnose, trehalose, D-xylose,
D-mannitol, mannose and D-sorbitol.
Negative results fo oxidase, lysine decarboxylase, Voges-Proskauer, phenylalanine,
gelatinase, deoxyribonuclease, lipase, acid production from: erythritol and
myo-inositol.

(c) Costin Stoica

| Antibiogram |
| Encyclopedia |
| Culture media |
| Biochemical tests |
| Stainings |
| Images |
| Movies |
| Articles |
| Identification |
| Software |
| R E G N U M PROKARYOTAE |
Differential characters of thespecies:
Legend: + positive 90-100%, - negative 90-100%, [+] positive 75-89%,
[-] negative 75-89%, d positive 25-74%, nd not determined.
[-] negative 75-89%, d positive 25-74%, nd not determined.
| Back |
| Citrobacter braakii |